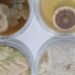
The Pros and Cons of DIY Mold Testing: A Homeowner's Guide

Sinusitis is a common condition that affects millions of people worldwide. It is an inflammation of the sinuses that can cause a range of symptoms, including nasal congestion, headache, facial pain, and postnasal drip. While there are many different causes of sinusitis, one possible culprit that is often overlooked is mold.

Mold is a type of fungus that grows in damp, humid environments. It is commonly found in bathrooms, kitchens, and other areas of the home where moisture is present. When mold spores are inhaled, they can cause a range of health problems, including allergic reactions, respiratory infections, and even sinusitis. In this article, we will explore the relationship between mold exposure and sinusitis, including the symptoms, causes, and treatment options for mold-related sinusitis.
Key Takeaways
- Mold exposure can cause or aggravate sinusitis symptoms.
- Symptoms of mold-related sinusitis are similar to those of other types of sinusitis.
- Treatment options for mold-related sinusitis include antifungal medications, nasal sprays, and sinus surgery.
Understanding Sinusitis and Mold Exposure
What Is Sinusitis?
Sinusitis is a common condition that affects millions of people worldwide. It is an inflammation of the sinuses, which are air-filled cavities located in the facial bones. Sinusitis can be caused by a variety of factors, including viruses, bacteria, fungi, and allergens. The condition is characterized by symptoms such as facial pain, headache, nasal congestion, and discharge.
The Role of Mold in Sinus Health
Mold is a type of fungus that can grow in damp and humid environments. Exposure to mold can cause a range of health problems, including respiratory issues such as asthma and allergies. Mold can also contribute to the development of sinusitis, especially in individuals with weakened immune systems.
Allergic fungal sinusitis (AFS) is a type of sinusitis that is caused by an allergic reaction to mold/fungus. Mayo Clinic found that 93% of patients with chronic rhinosinusitis (CRS) met the diagnostic criteria for AFS or sinusitis caused by an allergic reaction to mold/fungus. It was then postulated that an immune reaction to fungus in the sinus mucosa is likely responsible for AFS and most CRS. This fact was confirmed by Braun et al in 2003.
It has been demonstrated that patients who develop chronic illness after prior exposure to water damaged buildings (WDB) and mold have the presence of mycotoxins, which can be detected in the urine. It is hypothesized that the mold may be harbored internally and continue to release and/or produce mycotoxins which contribute to chronic illness.
It is important to note that not all individuals who are exposed to mold will develop sinusitis. However, those with weakened immune systems, allergies, or a history of respiratory issues may be more susceptible to the effects of mold exposure. It is recommended to take measures to prevent mold growth in indoor environments, such as keeping humidity levels low and fixing any leaks or water damage promptly.
Symptoms of Mold-Related Sinusitis
Mold-related sinusitis occurs when the sinuses become inflamed due to exposure to mold. Symptoms can range from mild to severe and can last for weeks or months. Here are some common symptoms of mold-related sinusitis:
Common Sinusitis Symptoms
- Stuffy nose
- Runny nose
- Congestion
- Postnasal drip
- Pain around the nose, eyes, and forehead
- Headache
- Cough
- Fatigue
- Fever
These symptoms are similar to those of other types of sinusitis, but mold-related sinusitis can be more persistent and difficult to treat.
Signs of Mold Exposure
In addition to the symptoms of sinusitis, exposure to mold can cause other allergy-like symptoms, such as:
- Sneezing
- Itchy nose, eyes, and throat
- Watery eyes
- Skin irritation
People with asthma may also experience worsening of their symptoms when exposed to mold.
It is important to note that not everyone who is exposed to mold will develop sinusitis or other health problems. However, if you are experiencing symptoms of sinusitis and suspect that mold may be the cause, it is important to seek medical attention. Your doctor may recommend allergy testing or refer you to an ear, nose, and throat specialist for further evaluation.
Causes and Risk Factors

Sinusitis is a common condition that can be caused or aggravated by various factors. Understanding the causes and risk factors can help individuals take preventive measures and seek appropriate treatment.
Mold as a Trigger for Sinusitis
Mold is a common trigger for sinusitis. Mold spores are present in both indoor and outdoor environments and can cause allergies and respiratory problems. When inhaled, mold spores can irritate the nasal passages and cause inflammation, leading to sinusitis. Individuals who are exposed to mold at home or work may be at a higher risk of developing sinusitis.
Environmental and Health Risk Factors
Apart from mold, several other environmental and health factors can increase the risk of sinusitis. These include:
-
Allergies: Allergies to pollen, dust, and other airborne particles can cause inflammation and swelling in the nasal passages, leading to sinusitis.
-
Immune system disorders: Individuals with weakened immune systems, such as those with HIV or diabetes, are more susceptible to infections, including sinusitis.
-
Structural abnormalities: Structural abnormalities in the nasal passages, such as a deviated septum or nasal polyps, can block the sinuses and cause inflammation.
-
Cystic fibrosis: Cystic fibrosis is a genetic disorder that affects the respiratory and digestive systems. Individuals with cystic fibrosis are at a higher risk of developing sinusitis.
-
Indoor and outdoor pollution: Exposure to pollutants such as cigarette smoke, chemical fumes, and smog can irritate the nasal passages and cause inflammation.
In conclusion, sinusitis can be caused or aggravated by various factors, including mold, allergies, immune system disorders, structural abnormalities, and pollution. Identifying and avoiding these risk factors can help prevent sinusitis and improve overall respiratory health.
Diagnosis of Mold-Induced Sinusitis
Mold-induced sinusitis can be difficult to diagnose as the symptoms can be similar to those of other types of sinusitis. However, a thorough clinical assessment is the first step in diagnosing mold-induced sinusitis.
Clinical Assessment
During the clinical assessment, the doctor will ask about the patient’s symptoms, medical history, and exposure to mold. According to the Mayo Clinic, common symptoms of sinusitis include facial pain, headache, nasal congestion, and postnasal drip. If the patient has a history of exposure to mold and is experiencing these symptoms, the doctor may suspect mold-induced sinusitis.
Imaging and Laboratory Tests
Imaging tests, such as a CT scan or MRI, may be ordered to examine the sinuses and identify any abnormalities. A CT scan is often the preferred imaging test as it provides detailed images of the sinuses. Laboratory tests, such as a culture of nasal secretions, may also be performed to identify the presence of mold.
It is important to note that not all cases of sinusitis are caused by mold, and not all cases of mold-induced sinusitis will show abnormalities on imaging tests. Therefore, a combination of clinical assessment and imaging and laboratory tests is often necessary to diagnose mold-induced sinusitis.
In summary, diagnosing mold-induced sinusitis requires a thorough clinical assessment, including a patient’s medical history and exposure to mold, as well as imaging and laboratory tests. If mold-induced sinusitis is suspected, it is important to seek medical attention promptly to prevent complications and ensure proper treatment.
Treatment Options

When it comes to treating sinusitis caused by mold, there are several options available. These include medications and antibiotics, surgical interventions, and alternative and supportive therapies.
Medications and Antibiotics
Antibiotics are often prescribed for bacterial sinusitis, but they are not effective against fungal infections. Antifungal medications such as amphotericin B may be prescribed instead. These medications are usually taken orally or administered through an IV.
In addition to antifungal medications, other medications may be prescribed to help manage symptoms. These may include decongestants, antihistamines, and nasal corticosteroids. These medications can help reduce inflammation and congestion, making it easier to breathe.
Surgical Interventions
In some cases, sinus surgery may be necessary to remove fungal growths or to repair structural abnormalities in the sinuses. This type of surgery is usually reserved for severe cases of chronic sinusitis that do not respond to other treatments.
Alternative and Supportive Therapies
There are also alternative and supportive therapies that can be used to help manage symptoms of sinusitis caused by mold. These may include:
- Nasal irrigation: This involves flushing out the sinuses with a saline solution to help reduce inflammation and congestion.
- Acupuncture: This traditional Chinese medicine technique involves inserting needles into specific points on the body to help reduce pain and inflammation.
- Probiotics: These are “good” bacteria that can help support the immune system and reduce inflammation in the body.
It is important to note that while alternative therapies may be helpful in managing symptoms, they should not be used as a substitute for medical treatment. It is always important to consult with a healthcare professional before trying any new therapies or supplements.
Overall, the best treatment for sinusitis caused by mold will depend on the severity of the condition and the individual’s specific symptoms and medical history. A healthcare professional can help determine the most appropriate treatment plan.
Preventing Mold-Related Health Issues

Mold exposure can cause a range of health problems, including sinusitis, allergies, and respiratory issues. To prevent mold-related health issues, it’s important to take steps to reduce your exposure to molds and fungi. This section will cover two main areas of prevention: environmental controls and personal health management.
Environmental Controls
To reduce your exposure to molds and fungi, it’s important to control the environment in which you live and work. Here are some tips to help reduce mold in your environment:
- Fix any leaks or water damage promptly.
- Keep humidity levels in your home below 50%.
- Use air conditioning or dehumidifiers during humid months.
- Ventilate bathrooms, kitchens, and laundry rooms.
- Clean and dry any damp or wet areas promptly.
- Use mold-resistant paint in areas that are prone to moisture, such as bathrooms and basements.
- Regularly clean and disinfect surfaces that are prone to mold growth, such as shower curtains and window sills.
Personal Health Management
In addition to controlling the environment, it’s also important to manage your personal health to reduce your risk of mold-related health issues. Here are some tips to help manage your health:
- Boost your immune system with a healthy diet, exercise, and adequate sleep.
- Wear a mask when cleaning areas with mold or fungi.
- Take allergy medication as prescribed by your doctor.
- Avoid exposure to mold and fungi as much as possible.
- Regularly clean and replace air filters in your home.
By taking these steps to prevent mold-related health issues, you can reduce your risk of sinusitis, allergies, and other respiratory issues. If you suspect that you have been exposed to mold and are experiencing health problems, consult with your doctor to determine the best course of treatment.
Complications and Long-Term Effects
Chronic sinusitis, especially when caused by mold exposure, can lead to several complications and long-term effects. These can be classified into chronic conditions and severe health outcomes.
Chronic Conditions
Chronic sinusitis can cause long-term inflammation of the sinuses, leading to chronic rhinosinusitis. This can cause a persistent feeling of congestion, pain, and pressure in the sinuses. In some cases, the lining of the sinuses can become permanently damaged, leading to further complications.
Severe Health Outcomes
Invasive fungal sinusitis is a rare but serious condition that can occur in people with weakened immune systems. This condition occurs when the fungal infection spreads beyond the sinuses and into surrounding tissues, potentially leading to serious health outcomes.
In some cases, mold exposure can also increase the risk of developing certain types of cancer, such as nasal and sinus cancer. However, the evidence linking mold exposure to cancer is not yet conclusive, and further research is needed to fully understand this association.
It is important to note that while mold exposure can cause or aggravate sinusitis symptoms, it is not the only cause. Other factors, such as allergies, bacterial infections, and structural abnormalities in the sinuses, can also contribute to the development of sinusitis.
If you suspect that your sinusitis symptoms are caused by mold exposure, it is important to seek medical attention. Your doctor can help determine the underlying cause of your symptoms and recommend appropriate treatment options.
Recent Research and Future Directions
Advancements in Sinusitis and Mold Research
Recent studies have shown that mold can be a contributing factor to sinusitis symptoms. According to a cross-sectional study based on NHANES 2005-2006, individuals with allergy symptoms were found to have a significantly higher incidence of sinusitis than those without allergy symptoms [1]. Another study conducted on patients with chronic rhinosinusitis (CRS) found that exposure to mold was associated with increased disease severity [2]. These findings suggest that mold should be considered as a potential cause or aggravating factor for sinusitis.
Advancements in mold research have led to new methods for detecting and identifying mold in indoor environments. Researchers have developed DNA-based techniques for identifying mold species, which can provide more accurate and comprehensive information about the types of mold present in a given environment [3]. This information can be used to develop more effective strategies for mold remediation and prevention.
Emerging Treatments and Preventive Measures
Current treatments for sinusitis caused by mold exposure include antifungal medications, nasal corticosteroids, and saline nasal irrigation [4]. However, emerging treatments such as immunotherapy and probiotics are showing promise in the treatment and prevention of sinusitis.
Immunotherapy, also known as allergy shots, involves exposing the patient to small amounts of allergens over time to desensitize the immune system. This can help reduce the severity of allergy symptoms and prevent sinusitis caused by mold exposure [5].
Probiotics have also been studied for their potential role in preventing sinusitis. Probiotics are live bacteria and yeasts that are beneficial to human health when consumed in adequate amounts. Studies have shown that certain probiotics can help reduce the incidence and severity of upper respiratory infections, including sinusitis [6].
In addition to these treatments, there are several preventive measures that individuals can take to reduce their risk of sinusitis caused by mold exposure. These include keeping indoor humidity levels below 50%, fixing any leaks or water damage promptly, and using air purifiers with HEPA filters to remove mold spores from the air [7].
Overall, advancements in mold research and emerging treatments offer hope for individuals suffering from sinusitis caused by mold exposure. By staying informed about current health topics and taking proactive measures to prevent mold exposure, individuals can reduce their risk of developing sinusitis and improve their overall health and well-being.
[1] https://www.ncbi.nlm.nih.gov/pmc/articles/PMC8710243/
[2] https://www.ncbi.nlm.nih.gov/pmc/articles/PMC7472891/
[3] https://www.ncbi.nlm.nih.gov/pmc/articles/PMC3942718/
[4] https://www.aaaai.org/conditions-and-treatments/library/allergy-library/fungal-sinusitis
[5] https://www.aaaai.org/conditions-and-treatments/library/allergy-library/allergy-shots-(immunotherapy)
[6] https://www.ncbi.nlm.nih.gov/pmc/articles/PMC5418896/
[7] https://www.cdc.gov/mold/dampness_facts.htm
Frequently Asked Questions
What are the common indicators of fungal sinusitis?
Fungal sinusitis is a type of sinus infection caused by the growth of fungi in the sinus cavities. The symptoms of fungal sinusitis may include nasal congestion, facial pain, headache, fever, postnasal drip, and cough. In some cases, fungal sinusitis may cause a loss of smell or taste, double vision, or blurred vision. If you are experiencing any of these symptoms, it is important to seek medical attention to determine the underlying cause.
How can one differentiate between bacterial and fungal sinus infections?
It can be difficult to differentiate between bacterial and fungal sinus infections based on symptoms alone. However, a doctor can perform tests to determine the underlying cause of the infection. These tests may include a physical examination, imaging tests, and laboratory tests. In some cases, a biopsy may be necessary to confirm the presence of fungi in the sinus cavities.
What methods are effective for eliminating mold from the sinus cavities?
Treatment for fungal sinusitis typically involves antifungal medication and, in some cases, surgery to remove the infected tissue. In addition, it is important to eliminate the source of the mold to prevent the infection from recurring. This may involve identifying and addressing sources of moisture in the home or workplace, such as leaks or high humidity levels.
Can living in a mold-infested environment lead to sinus issues?
Exposure to mold can cause a variety of health problems, including sinus issues. Mold spores can irritate the nasal passages and cause inflammation, leading to symptoms such as nasal congestion, sneezing, and runny nose. In addition, exposure to mold can trigger asthma symptoms in people with asthma.
What are unconventional symptoms that might suggest mold exposure?
In addition to the common symptoms of sinusitis, exposure to mold can cause a variety of unconventional symptoms, such as fatigue, brain fog, and joint pain. These symptoms may be more common in people with preexisting health conditions, such as allergies or asthma.
Are there natural remedies effective against mold-related sinusitis?
While there is no cure for mold-related sinusitis, there are natural remedies that may help alleviate symptoms. These may include saline nasal rinses, steam inhalation, and herbal supplements such as echinacea and goldenseal. However, it is important to consult with a healthcare provider before using any natural remedies, as they may interact with other medications or have harmful side effects.